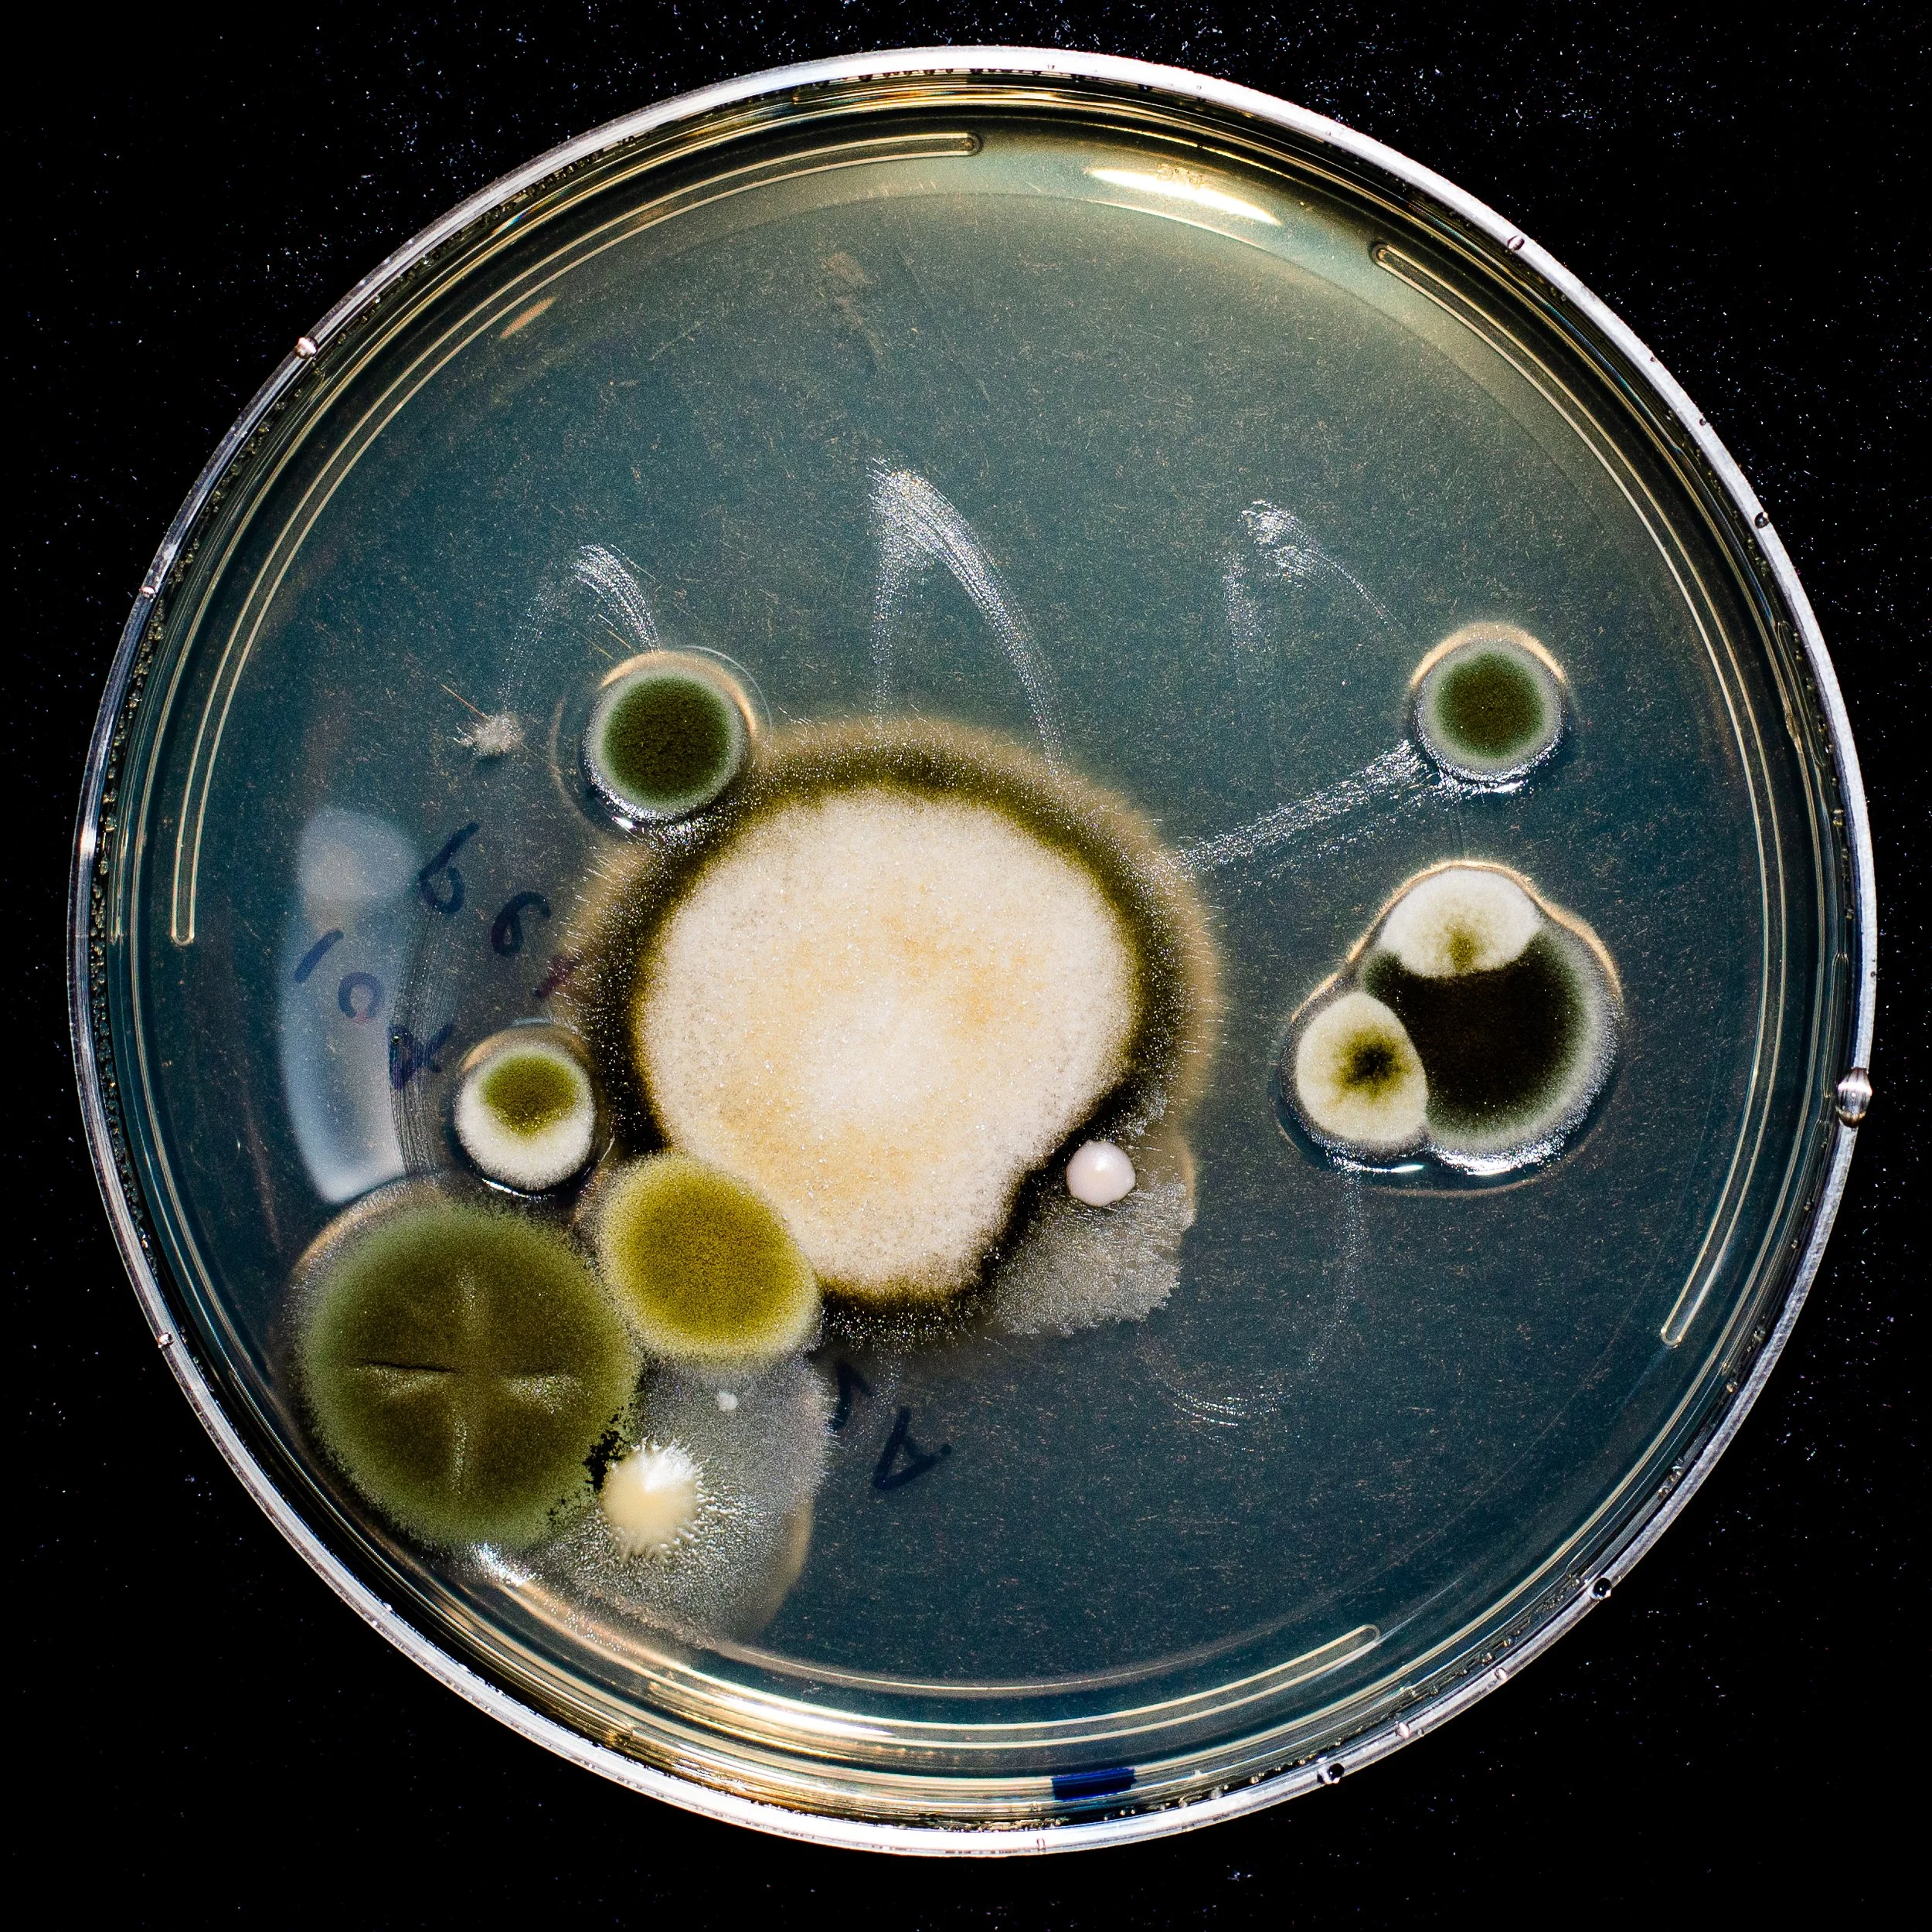

PhD Dissertation Defense
I finished my PhD!
Cyanotype poster of my PhD defense (see below for more information about the process to make them below).
On February 17th 2023, I defended my dissertation entitled Coloring outside the lines: Community assembly in the life sciences. This PhD defense represented the culmination of my work. Over the past five years, I’ve been studying communities —both communities of nectar-inhabiting microbes in California wildflowers and communities of scientists seeking to make the world a better place. Now, I’m officially a community ecology and PhD (Dr. Callie!).
My dissertation defense had several parts: a research talk, a hands-on art workshop, an art exhibition, a piano duet with my advisor, and a happy hour/party. To celebrate all components, I wanted to put together a blog post with videos, photos, and more information. Scroll down for sections about each of the events!
How does a PhD work?
A PhD (doctorate degree) is typically 4-6 years long and consists of doing research with a professor at a university (known as a PhD advisor) and sometimes taking coursework. My PhD was from the Department of Biology at Stanford University (Ecology and Evolution) and my PhD advisor was Tadashi Fukami. I started by PhD in 2017, after completing bachelor’s (Biology) and master’s (Molecular, Cellular, & Developmental Biology) degrees from the University of Michigan. My PhD research focused on studying the ecology and evolution of nectar-inhabiting yeast in the sticky monkey-flower (Diplacus aurantiacus). I was also very involved in science art, education, activism, and policy during my PhD. At the end of a PhD, a PhD student’s work culminates in producing a thesis (which will be available soon online) and a defense talk, which is evaluated (after questioning) by a committee of professors.
Typically, the thesis and defense talk focus exclusively on the academic research conducted during the PhD by the student. However, because of my expansive non-scientific research work, I wanted to highlight that work as well. I believe that dissertations in STEM should be more expansive in what we consider science to be. To this political end, it was important in my dissertation, to expand what we imagine a dissertation to look like.
But first, gratitude:
My PhD advisor Tadashi Fukami (right) and I after my PhD defense.
None of this would have been possible without an incredible community of people supporting me. In particular for my dissertation defense, I want to acknowledge my amazing PhD advisor (and duet partner), Tadashi Fukami, committee members Lauren O’Connell, Kabir Peay, Moi Expósito-Alonso, and external chair, Drew Endy.
The art exhibition and workshop was inspired by and led by Corinne Okada Takara (lovingly referred to as my “other advisor”). The workshop was co-designed with Melissa Ortiz. Art pieces were envisioned with Corinne. Photography was printed by Evan Dorsky and two exhibited pieces were Evan’s original photography of artwork displayed at the California Academy of Sciences. The art components were also supported by Nasa Sinnott-Armstrong and James Lawniczak.
Videography and photography were led by Evan Dorsky and Paul Wintz.
Full acknowledgments for my PhD journey will be available soon in my dissertation.
Defense Talk
The primary part of a PhD defense is a talk where the PhD candidate shares their research over the course of their PhD to their PhD committee and colleagues. In my defense talk, I wanted to highlight my academic research and activism work, focusing on BioJam. The talk is about 40 minutes long and starts at the 10 minute mark in the video below.
More than 50 people attended the talk in person and over 80 friends, family, and colleagues joined on Zoom. Thank you for joining, if you were able to come!
Dissertation abstract:
My dissertation is focused on studying the assembly of both ecological and social communities in the life sciences. First, I aimed to reimagine the current scientific enterprise within its own terms. By publishing scientific papers that center scientific art (Ch. 1), intergenerational mentorship (Ch. 2), and celebration of diverse lived experiences within academic science (Ch. 3), I show that science can flourish from diverse, equitable, and interdisciplinary groups. The topic of this research focuses on the assembly of microbial communities in the nectar of Diplacus aurantiacus (Ch. 1). By applying population genetics, functional genomics, and experimental evolution to this wild microbiome, I identify mechanisms that connect genetic variation to community-level processes such as priority effects (Ch. 2) and show that population-level variation can alter molecular traits associated with community assembly (Ch. 3). Second, I question the academic structure itself as the central nexus for scientific discovery. By dissolving the duality between science and art (Ch. 4), creating new science spaces that center culture and lived experience (Ch. 5-6) and reimagining entire educational ecosystems outside of “traditional” scientific venues (Ch. 7), I propose new frameworks for how science can be conducted and perhaps, what we consider science to be. This work is centered in community-centered art/science programming in the Greater Bay Area of California. In total, I hope this dissertation highlights how the life sciences can flourish when we celebrate a diversity of perspectives and approaches.
Published chapters:
Chapter 1: C. R. Chappell, T. Fukami, Nectar yeasts: a natural microcosm for ecology. Yeast. 35, 417–423 (2018).
Chapter 2: C. R. Chappell, M.K. Dhami, M.C. Bitter, L.C. Czech, S.H. Parades, F.B. Barrie, Y. CalderónX, K. Eritano, L-A. Golden, D. Hekmat-Scafe, V. Hsu, C. Kieschnick, S. Malladi, N. Rush, T. Fukami, Wide-ranging consequences of priority effects governed by an overarching factor. eLife 11, e79647 (2022).
Chapter 4: C. R. Chappell, & L. J. Muglia, Fostering science–art collaborations: A toolbox of resources. PLOS Biology 21, e3001992 (2023).
Chapter 5: C.R. Chappell, R.C. Perez, C. Takara*, Bioengineering everywhere, for everyone. Issues in Science and Technology. 38, 3, 88-90 (2022).
Watch my defense talk here:
Videography by Evan Dorsky (2023).
Art Workshop
Science superpowers: Reimagining biological mythologies
Video credit: Evan Dorsky (2023)
At the end of the talk, I posed a question to the audience: “What is the scientific community that you dream of?” To actualize these dreams, I designed a hands-on art workshop. This workshop was taught by Corinne Okada Takara, a community bio artist and educator, and co-designed between me, Corinne, and our friend and artist Melissa Ortiz. Unfortunately, I was not present during the workshop because I was being examined by my committee in a different room.
You can see the workshop slides here.
This hands-on activity invited a playful reimagining of science “superpowers” through taking inspiration from our lived experience, culture, and biology. Participants took inspiration from the mythological and biological concept of a chimera. Chimeras are hybrids that take parts from biological creatures and our own cultural imagination to embody imaginative traits.
What are the traits that we imagine to represent our science superpowers? What are the cultural, biological, and political references we can create chimeras of to represent these traits?
Participants created small statues/idols of our chimeras using an unexpected material, recycled lab plastics, to re-envision what science is and can be. By repurposing materials (plastics) that represent the status quo of science and colonial pollution, I wanted to reimagine them–through recycling– and us, as scientists, into the liberatory and transformative futures of our dreams.
These statues/idols take cultural inspiration from Oaxacan Alebrijes, carved wood sculptures that represent mythical creatures (reflecting the cultural heritage of many BioJam teens), Japanese Yuru-chara (ゆるキャラ), kawaii (cute) mascot characters that promote the identity of a place or group (reflecting the cultural heritage of two of my mentors, Corinne Takara and Tad Fukami), and European corn mothers, Germanic folk art made of natural materials that represent the biological spirit of the harvest in human form (reflecting my cultural heritage of northern Europe).
All workshop photography was done by Evan Dorsky (2023) and Paul Wintz (2023).
Part 1: Brainstorming
First, participants were asked to brainstorm “science superpowers” on sticky notes at their tables and share with the group.
Then, they were asked to choose one trait for the mythical creature they designed. They then brainstormed biological inspirations to represent the trait they chose. They prototyped their mythical creatures by sketching designs on their table.
Part 2: Building and Creating
Next, participants made the creatures they designed from recycled lab materials donated by several labs in our department. Using hot glue and super glue, they rummaged through bags of tubes, thin film plastics, pipette tips, and many other materials to create their chimeric creatures.
Thank you to the following labs for donating materials:
Shen lab
Luo lab
Fraser lab
Petrov lab
Mordecai lab
Kopito lab
Peay Lab
O’Connell lab
Fukami lab
Part 3: Final designs
Tree with a Puerto Rican Vejigante mask (Seba Toro (2023)).
Participants made amazing final designs!
For example, one person made a photosynthetic bison-whale to represent creativity and curiosity. This organism creates songs and whole ecosystems on its back by traveling in herds—in community.
Another person designed a tree with a Puerto Rican Vejigante Mask to represent the intersection of community and sustainability through sustainable agriculture in Puerto Rico (pictured).
Enjoy this gallery of some of the creations. Photography by Paul Wintz (2023).












Art Exhibition
In addition to the talk and art workshop, I also exhibited several pieces of original art about nectar-inhabiting microbes. See below for photographs and more information about each art piece!
Defense Invitation Cyanotypes
Photography: Evan Dorsky (2023)
I made over 50 individual cyanotype prints (sunprints) with transparencies of nectar microbes (scanning electron microscopy images, pictures of agar plates) and sticky monkeyflowers, as well as live plant materials. These invitations were mailed to friends and family across the US, as well as used to advertise my defense. This project was supported by Melissa Ortiz, Evan Dorsky, and James Lawniczak. Special thanks to Evan Dorsky for providing materials for this project.
Nectar Microbes Infographic
In 2018, I designed an infographic poster about nectar microbes that explains their relationship connecting plants and pollinators. This infographic poster has been used in presentations at the California Academy of Sciences and is displayed outside the Fukami lab.
Infographic poster at defense with additional art pieces (photo: Evan Dorsky 2023)
Fukami lab presenting at Cal Academy (2022)
Microbial DNA Music box
In the lab, we identify the species of each nectar inhabiting microbe by growing them on agar petri dishes, extracting their DNA, and sequencing them. To show the DNA sequences used to identify each species, I translated a section of their DNA sequence into musical notes which could be played on a music box.
This project was conceptualized with Corinne Okada Takara (2021).
Artist Statement:
We sequence the DNA of microbes we grow in the lab to identify their species. This music box plays a translated version of the DNA sequence used to identify the focal species of Callie’s research, the nectar yeast Metschnikowia reukaufii.
Stanford undergraduates growing nectar microbes in agar petri dishes from field-collected flowers.
Photography: Callie Chappell (2022)
Nectar microbe DNA music box with nectar microbes growing on agar petri dishes.
Photography: Callie Chappell (2022)
People at Cal Academy looking at nectar microbes growing on petri dishes through a microscope.
Photography: Evan Dorsky (2022)
Nectar Microbe window plate decals
I took high resolution images of agar plates growing nectar and petal microbes, which I printed on large vinyl transparency stickers as a window display. These decals will be permanently displayed in the Fukami lab.
Nectar microbe plates were grown by BIO 47 undergraduate students in spring 2022.
Artist statement:
These semi-transparent window decals are photographs of agar plates growing microbes isolated from Sticky Monkey-Flower nectar and petals. Plates were cultured by BIO 47 students.
Metacommunity Biocircuit
Video taken by Corinne Takara (2022).
To illustrate how pollinators such as hummingbirds move nectar microbes from flower to flower, Corinne and I created a biocircuit. By touching sticky monkeyflowers and holding a grounding cable, participants close a circuit and the sound of a hummingbird plays. This biocircuit was created using makey makey. The code was developed in Scratch by Corinne Takara.
This is a modified activity from BioJam camp.
Artist Statement:
Pollinators, such as hummingbirds, move nectar-inhabiting microbes from flower to flower. Like a pollinator, you can connect flowers by creating a biocircuit with your body.
By firmly touching one hand to a flower (that is attached to the MakeyMakey) and your other hand to a grounding cable (also attached to the MakeyMakey), you can complete a circuit with your body.
When the circuit is completed, it will run Scratch code on the computer attached to the MakeyMakey to make a hummingbird sound. Different flowers will make different sounds, reflecting the differential pollination of flowers based on their microbial community.
Monkeyflower Oral History
Since many members of my global community couldn’t attend my defense, I created a “oral scrapbook” with sound recordings and messages from friends, family, mentors, and loved ones. For the in-person audience, people could record their ideas into a microphone within a large metal armature of a sticky monkey-flower.
Email me if you wish to send a recording!
monkeyflower Quilt
I asked a selected group of friends (many of whom where textile artists) to contribute to a collaborative piece of artwork for my defense: a quilt! The idea to sew a quilt was originally suggested by Abby Birnbaum and supported by Pagé Goddard. Corinne Takara helped me design the quilt and encouraged me to use Spoonflower to print a custom fabric depicting the plant species I studied (Diplacus aurantiacus). 15 friends helped sew/design each individual quilt square: (1) Melissa Ortiz, (2) Merrily Bauer, (3) Lining Wang, (4) Abby Birnbaum, (5) Corinne Takara, (6) Jess Martin, (7) Pagé Goddard, (8) Caroline Daws, (9) Wanyi Dai Li, (10) James Lawniczak, (11) Rolando Perez, (12) Jen Marrero Hope, (13) Alex Ferris, (14) Zach, Jean, Ruby, and Shep Rodgers, and (15) Nasa Sinnott-Armstrong. Jen Marrero Hope helped me sew the final quilt.
Artist Statement:
This quilt represents some of the many formative people who have supported me throughout my PhD. With an emphasis on friends with familiarity working with textiles, this quilt represents emergent properties that come from the diverse communities that inhabit the focal plant of my research, the Sticky Monkey-Flower (Diplacus aurantiacus). The individual communities of bacteria and yeast that can inhabit flowers are represented by the colorful border.
See below for close-up images of selected squares and artist statements (click to read):
Piano Duet
Both Tad and I play the piano and we prepared a short duet to play together after my closed door session. We played part of Slavonic Dance Op. 72 by Antonin Dvorak. We chose this piece because Dvorak was an immigrant to the US but contributed greatly to the American musical tradition. Similarly, Tad and I hope to contribute to the American ecological tradition through our work.
To introduce the piece, Tad said:
In the short piece Callie and I are going to play, we will start nice and quiet and then go to the climax. I will be supporting Callie as well as I can, but then in the end, it will be Callie who will be supporting and guiding me, sort of like how it went between us over the past five years. The piece is sad, but pretty and beautiful, just like a good dissertation, like Callie's.
Celebration
After the planned activities, we enjoyed Thai food and a happy hour with snacks. I was very fortunate to celebrate with my departmental community, friends, and my committee.
My friend Kelley Langhans baked an amazing honey cake to share and we drank craft Kombucha from a local brewery, Fox Tale Fermentation Project.
Thank you to everyone who came out!
Dissertation
My complete dissertation is available here, but you can read the introduction below and published chapters here:
Chapter 1: C. R. Chappell, T. Fukami, Nectar yeasts: a natural microcosm for ecology. Yeast. 35, 417–423 (2018).
Chapter 2: C. R. Chappell, M.K. Dhami, M.C. Bitter, L.C. Czech, S.H. Parades, F.B. Barrie, Y. CalderónX, K. Eritano, L-A. Golden, D. Hekmat-Scafe, V. Hsu, C. Kieschnick, S. Malladi, N. Rush, T. Fukami, Wide-ranging consequences of priority effects governed by an overarching factor. eLife 11, e79647 (2022).
Chapter 4: C. R. Chappell, & L. J. Muglia, Fostering science–art collaborations: A toolbox of resources. PLOS Biology 21, e3001992 (2023).
Chapter 5: C.R. Chappell, R.C. Perez, C. Takara*, Bioengineering everywhere, for everyone. Issues in Science and Technology. 38, 3, 88-90 (2022).
Introduction:
Science is stories.
It’s the stories we tell ourselves when we were children,
about donning a white lab coat,
about intrepid discovery.
Is that science?
Maybe science isn’t that.
Maybe it is the glint of dew off a fiddlehead fern.
Maybe it is the scent of pine. terpenes.
Maybe it is the art of looking,
of curiosity,
of the joy of discovery.
Somehow, that feels right.
We need new stories in science.
Because the stories of science
are just stories of us.
I have always been fascinated by how communities assemble and change over time. The stochastic and deterministic factors that shape the trajectories of communities –both ecological and social–also shape the contours of our lives as scientists. In my PhD, I studied these mechanisms that structure how communities assemble over time. In the subsequent chapters, you will read about changing ecological communities of nectar-inhabiting microbes that inhabit the floral nectar (Chapters 1-3) and social communities of scientists in the Greater Bay Area of California (Chapters 4-7). Yet, the driving force behind this work are stories: the stories we tell ourselves about why communities change and why that change matters.
Let me begin by sharing my story.
I grew up on the shores of Lake Michigan. I swung on birch trees and grabbed rainbow trout out of streams with my bare hands. I picked wild crab apples to bake with my grandma. In the spring, I carefully sketched newly opened trillium flowers. It’s a trope in our field that for many of us, these formative outdoor experiences inspired us to become ecologists. Yet for me, it inspired me to become an artist. Being out in the world, smelling the forest and appreciating its beauty–that felt firmly in the world of art. Only many years later did I recognize that it was also science.
At the time, science felt like an intellectual sport. First, it was a competition for grades, to prove who was the “smartest.” Then, it was a different kind of competition, for the most elite departments, to publish in the most prestigious journals. But it was a competition I felt like I could never win. I was too femme, too small, and too friendly. I liked taking care of people. I didn’t care about eliteness but felt like I had to perform it in order to be respected by my peers. Yet my peers rarely shared my experiences as a person of color, an immigrant, an adoptee, an orphan, a queer person, a person from the countryside. This normative world of the scientific elite felt so far from the cabin with a wood-burning stove I grew up in, a lake full of painted turtles in my backyard. This academic world felt so different from the world of art teachers who taught me how to observe like a naturalist, how to listen to the world and share my observations through drawings, stories, and later, data. To them, to be a scientist was to find joy in curiosity and spread joy by sharing that curiosity with others. Halfway through my PhD, I wondered why science couldn’t be more like art. Why did it have to be “objective”, and what does objectivity really mean?
The dogma of objectivity in science has deep historical roots. During the development of the modern American scientific research enterprise, promoting science as objective and impartial was necessary to support the national security apparatus1,2. If science was a political or subjective endeavor, what epistemological privileges would scientists hold over other knowledge-holders, say, political activists, artists, or communities of color3? While this dissertation is not a critique of the framework of objectivity, it does beg the question: what is the role of identity, culture, and power in the scientific enterprise?
The perspective of science as an objective endeavor doesn’t hold up to our lived experience as scientists. We are not disembodied brains in vats trying to make sense of data. Every science practitioner knows that our personal preferences, limitations, identities, and perspectives play a central role in our work. Why did I run the experiment for three weeks instead of four? Because a friend passed away and I needed to fly home for the funeral. Why did I choose to do fieldwork at this location? Because it was within biking distance and I couldn’t afford a car. Why did I choose this particular statistical approach? Because a postdoc in the lab knew how to do it and gave me their code. Science is personal. Science is also political. The political context we operate in—funders, political will, even the politics of identity—direct our research programs in major ways. Yet, failing to acknowledge these as central elements in our scientific practice is failing to account for a major explanatory variables that shape our results.
To center both the personal and political into the narratives we tell about science, we can tell stories. Stories connect our lived experiences with the research we produce. They shape how we understand the world and they persuade others to believe us4–6. I wrote this introduction as a series of stories, woven together into the tapestry of my dissertation. I believe that stories play a crucial role in shaping the frameworks in which we operate and open the possibility of crafting new ones. To this end, I want to share the stories behind the chapters of my dissertation.
In Chapters 1-3, I used a system of nectar-inhabiting microbes to study how the assembly of ecological communities is dependent on their histories. Like human societies, the trajectory of ecological communities over time is altered by arrival order, environmental modification, and chance. You will read about our experiments, research findings, and interpretations in the subsequent chapters, but here, I wish to highlight the stories behind the work. The idea of historical contingency, where stochasticity can alter the assembly of ecological communities, rang true to my own life. As an international adoptee from China, my adoption into an American family is the epitome of a stochastic process that altered my life’s trajectory. I grew up in rural Northern Michigan where it was undeniable that my race, class, and gender shaped who I have become. Identity was central to how I have been able to operate in science and in my academic work. I have tried to make visible the often invisible ways that identity shapes the research we do. For example, the research presented here has been conducted collaboratively with a diverse, intergenerational team. In particular, I want to acknowledge the work of a team of undergraduates (Team Nectar Microbe) which primarily consist of paid, first generation, low-income students. Through the years, we learned together how to create a collaborative and co-designed team. We jointly designed and conducted experiments and created a supportive community. We wrote team values statements, created community engagement projects in addition to our research, and developed our own group meetings. Team members were primarily based at Stanford, but also expanded to other institutions including HSIs (CSU Northridge, University of Arizona, UC Santa Barbara) and a community college (Cañada College). Through generous sharing by these undergraduates, I saw even more clearly how academia recapitulates structural oppression. How could I encourage these students to pursue careers in STEM when I saw my peers, who shared many of their same identities, be systematically harmed around me? First, I tried to improve the academic structures we were embedded in. I was involved in starting the first informal DEI committee for the Biology Department in 2019, then as a member and later chair of the graduate council of my professional society, the American Society of Naturalists. Doing this work, I saw many good people trying to make academia a better place for all. But they were constrained by deans, funding, their colleagues, and their own experience. I wondered, are there spaces outside of academia, or in collaboration with academia, where we could reimagine more just science from the ground-up?
Chapters 4-7 highlight my work doing just that. To reimagine science, I started with art. Art is traditionally considered disjoint from science, even one of “two cultures”7. However, my personal story showed me that art is, in fact, quite similar, if not the same, as science. After all, it was sketching nature that taught me how to observe the world like an ecologist. Throughout my PhD, my art skills increased my efficacy as a scientist. From illustrating figures, to teaching workshops on science communication, my professional life as an artist became central to my identity within the scientific community. I wondered if I could show scientists that art isn’t just a way to communicate science, but that science is in fact a creative process that is a form of art, I could get them to reimagine what they considered science to be. Chapter 4 makes this argument. Seeing art as a starting point for reimagining science was the genesis of BioJam. BioJam is a radical education program I became involved in, later ran, and now have passed onto another generation. Chapters 5 and 6 describe how BioJam functions as a political project that reimagines biology from the perspective of lived experience, culture, and ancestral knowledge. Co-founded by artist Corinne Takara and then-PhD candidate in Bioengineering Rolando Perez, we created an arts organization that empowers youth and their communities to make with biology. By using community co-design, transdisciplinary thinking, and culturally-relevant pedagogy, we also transform the ways that academics interact with their own scientific knowledge production. By positioning youth activists as leaders/teachers and scientists as supporters/learners, we fostered a space that wasn’t merely advancing diversity, equity, and justice from status quo institutions, but creating a decolonial collective from the ground-up. While single programs like BioJam can be transformative for the individuals involved, in order to catalyze broader change, we must work at the regional, national, and international scales. In Chapter 7, I write about how programs like BioJam can be embedded in regional community biodesign ecosystems. These ecosystems consist of interdisciplinary spaces such as maker spaces, community bio labs, informal learning spaces, and academic labs. Collaborations across these spaces and communities can help us reimagine the spaces where science exists. Instead of exclusively in academic labs, community-based biodesign ecosystems highlight the biology already being done in our own communities: in kitchens, gardens, libraries, parks, and more. Together, these dissertation chapters (Ch. 4-7) highlight how, by starting with art, a different scientific community can assemble: one that is based in grassroots community, intergenerational knowledge, and decolonial.
I hope that this dissertation shows my colleagues–present and future–that being a scientist can be more than we ever imagined. Not only can scientists come from a diversity of lived experiences and identities, but what science can look like can range from laboratory experiments to community art projects. This dissertation is, in and of itself, a political act. It is meant to reimagine what a PhD in the sciences is, and to be a step in the process of imagining what it can be. In accepting this, you are affirming that science isn’t just what we do, but who we are. The process of community assembly isn’t just stochastic, but also deterministic. The ways species interact, the environmental context, dispersal between communities matter. If we seek to support communities that are diverse, well-functioning, and stable, we cannot simply study them, we must act.
Literature Cited
2. Wolfe, A. J. Freedom’s Laboratory. (2020). doi:10.1353/book.99572.
7. C. P. Snow. The two cultures. (Cambridge University Press, 2001).